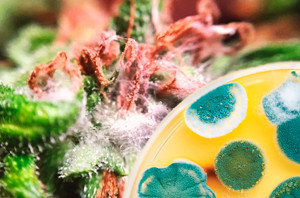
конопля плесень

Выращивание каннабиса – это настоящее искусство, которое требует определенных знаний и навыков. Постигать это искусство можно многие годы, ведь совершенству нет пределов. Ошибки на этом пути

Выращивание каннабиса – это настоящее искусство, которое требует определенных знаний и навыков. Постигать это искусство можно многие годы, ведь совершенству нет пределов. Ошибки на этом пути

Плесневые грибки появились на нашей планете более 200 тыс. лет назад. Они распространены повсеместно – в воздухе, в открытом грунте, в воде. Эти грибки появляются из спор и могут поражать ра
Кусты культурного каннабиса отличаются высокими декоративными качествами. Однако профессиональные гроверы не столько любуются, сколько оценивают их структуру с точки зрения урожайности. Основной и

Все сортовое многообразие марихуаны базируется на трех основных видах: сатива, индика, рудералис. Они существенно различаются по внешнему виду, степени стрессоустойчивости, эффекту от употребления

Стелс-гровинг – это способ выращивания конопли, при котором никто из окружающих не должен догадаться о растишках. Название этого способа культивации происходит от английского «stealth&

Еще каких-то 150 лет назад вопрос о том, можно ли сочетать марихуану с приемом антибиотиков, не мог даже возникнуть. По той простой причине, что антибиотики еще не были известны человечеству. Сего

Вопрос о времени, в течение которого следы марихуаны полностью выводятся из крови, волнует многих ценителей каннабиса. Особенно актуален он для тех, чья ситуация так или иначе связана с проведение

Афганская конопля известна своей убойной силой воздействия, высокой живучестью и узнаваемым ароматом. Благодаря этим качествам, афганка вот уже на протяжении многих лет стабильно находится в топе

Марихуана славится прежде всего своим эйфорическим эффектом, которым определенные сорта растения обязаны высоким содержанием ТГК (THC) или тетрагидроканнабинола. Именно такими гибридами больше все
